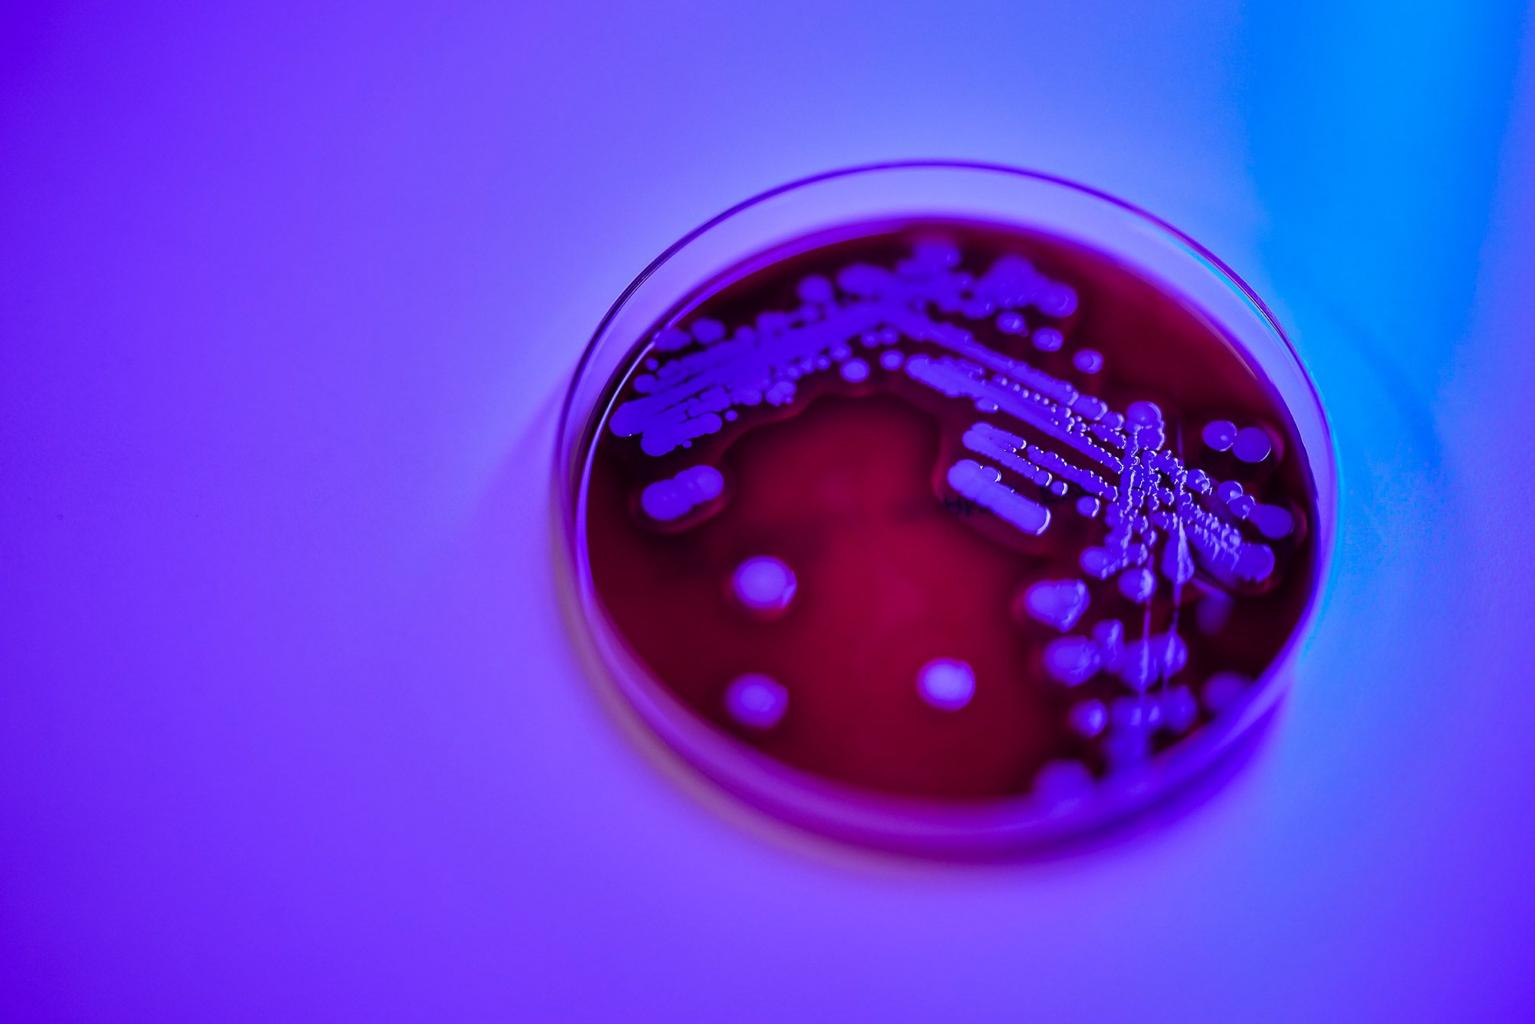

New species of bacteria named after Singapore
Sign up now: Get ST's newsletters delivered to your inbox
The discovery was published in the International Journal of Systematic and Evolutionary Microbiology on Oct 26, 2021.
PHOTO: NATIONAL UNIVERSITY HOSPITAL
Follow topic:
SINGAPORE - An unexpected discovery by a team of doctors analysing skin and wound samples has led to a new species of bacteria being identified and named after Singapore.
Staphylococcus singaporensis sp.nov (S. singaporensis) is part of the Staphylococcus aureus (S. aureus) complex, which commonly causes conditions from mild skin and wound infections to surgical and more serious bloodstream infections that may be fatal.
The discovery was published in the International Journal of Systematic and Evolutionary Microbiology on Oct 26.
This complex is a group of four different species, including S. singaporensis, that have a similar genetic make-up.
Associate Professor Raymond Lin, director of the National Public Health Laboratory at the National Centre for Infectious Diseases (NCID), said on Tuesday (Dec 14) that everyone will likely be infected by S. aureus at some point in their lives.
To isolate and identify the Singapore bacteria, research groups from the National University Hospital (NUH), NCID and Singapore General Hospital had studied bacteria isolates, which appeared related to S. aureus, between April 2019 and July 2019.
Isolates are bacteria grown in a laboratory.
Whole genome sequencing of the isolates was then performed and comparative genome analysis found that six out of the 43 of these isolates were quite different from other members of the S. aureus complex.
These six isolates were confirmed to be a new species - the Singapore bacteria.
"This new species probably existed all along and nobody noticed it earlier," Prof Lin, who is also the head and senior consultant in microbiology at the Department of Laboratory Medicine in NUH, said.
Based on what is known so far, the new species is susceptible to commonly used antibiotics, unlike some S. aureus species that have developed multi-drug resistance.
S. singaporensis also lacks many of the toxin genes frequently found in S. aureus.
However, more data needs to be collected over time, both locally and globally, to fully understand the impact of the new species.

(From left) Dr Chew Ka Lip, NUH Department of Laboratory Medicine principal scientific officer for microbiology Dr Jeanette Teo and Associate Professor Raymond Lin, who were part of the team that discovered the new species.
PHOTO: NUH
Identifying a new species enables scientists to analyse and predict more precisely the outcomes of infections due to various species, Prof Lin added.
Dr Chew Ka Lip, a consultant in microbiology at NUH's Department of Laboratory Medicine, added: "There remains much to be done to understand the differences, if any, between these organisms in terms of clinical infections and prognosis.
"This could potentially lead to more tailored clinical care management of our patients to optimise outcomes.
All six isolates have also been deposited in international strain repositories.

